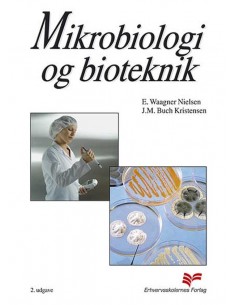
Mikrobiologi og bioteknik

Your cart
Es gibt keine Artikel mehr in Ihrem Warenkorb
Studiebøger
Skole- og lærebøger diverse
Sikkerhedshåndtering
Skole- og lærebøger diverse
Tandklinikassistent - hovedforløb
Skole- og lærebøger diverse
Trendsociologi v. 2.0
Skole- og lærebøger diverse